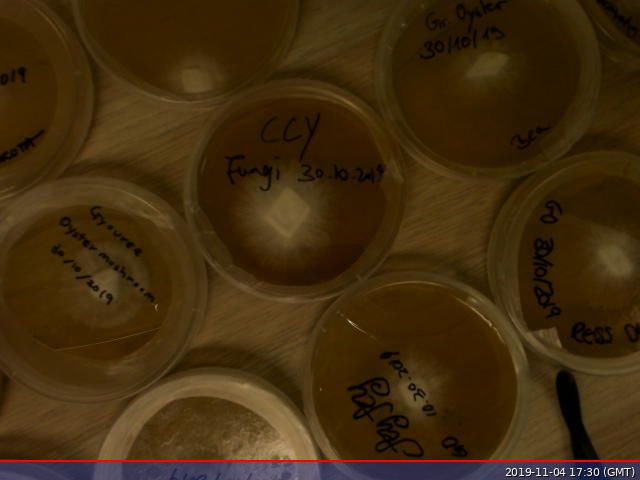
Open Cell London tweet media

ทวีตที่ปักหมุด

Learn more about the #cellfree technology behind our company.
cell-free.tech has a new lab in Open Cell London.
English
Cell-Free Technology
2K posts

@cellfreetech
We break cells open and code with DNA. We use #cellfree to rapidly prototype proteins for researchers and we build #openscience tools for everyone.

Support via @kickstarter 🍄kck.st/32zXUfe🍄 Coffee cups are hard to recycle. @blast_std use mycelium bioremediation to turn trash into vases! @icoffeeclub @CircularEClub @CEC_LDN @RebelBio @ebenbayer @SynBioBeta @mnlimas @heathercorc @rosscloney @Cesiboy1
